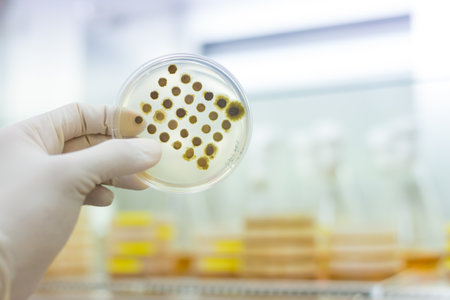
Scientist growing bacteria in petri dishes on agar gel as a part of scientific experiment. Development of virus treatment drug.の写真素材

写真素材 - Scientist growing bacteria in petri dishes on agar gel as a part of scientific experiment. Development of virus treatment drug.
作品情報
Scientist growing bacteria in petri dishes on agar gel as a part of scientific experiment. Development of virus treatment drug.
- ID:259779832
- 作品種別:写真
- 作者名:Matej Kastelic
キーワード
- agar
- analysis
- analyze
- bacteria
- bacteriology
- bacterium
- biochemistry
- biological
- biology
- cell
- culture
- drug
- experiment
- fungi
- fungus
- grow
- health care
- healthcare
- infectious
- laboratory
- medical
- medicine
- micro
- micro organism
- microbe
- microbiology
- pandemic
- pathogen
- pathology
- petri dish
- plate
- research
- science
- scientific
- strain
- technology
- test
- transparent
- treatment
- virus
類似作品
Cells that caus...
Science and Lif...
Close-up of bac...
bacteria colony...
Medicine, scien...
Women scientist...
Examining bacte...
bacteria colony...
Dynamic motion ...
Scientist hand ...
Science and Lab...
Green bacteria ...
Backgrounds of ...
Science and Lif...
Macro close up ...
Bacteria or mic...
Conceptual imag...
Close-up of ger...
High-definition...
Close-up of a s...
Petri dish with...
High-res image ...
bacteria colony...
epidemic and th...
Scientist hand ...
Petri Dish Cult...
Red bacteria on...
bacteria colony...
A researcher do...
High-definition...
Researcher hand...
Bacteria and mi...
A detailed digi...
close-up of res...
round glass to ...
Bacteria on a s...
Research of vir...
close-up of bac...
Gloved hand hol...
Close-up of ger...
Petri dishes in...
High-res image ...
Surface with ba...
petri dish with...
Anthrax.
Pichia is a gen...
epidemic and th...
Laboratory assi...
Scientist exami...